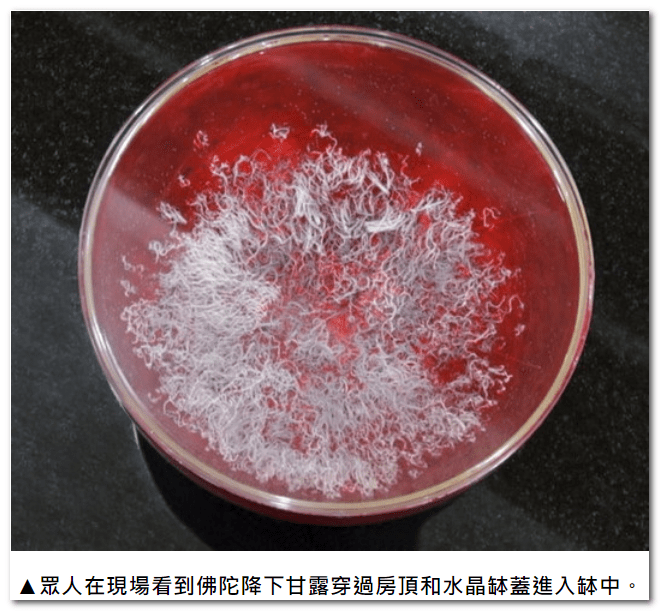
第三世多杰羌佛

第三世多杰羌佛說法《藉心經說真諦》
佛陀們認證了第三世多杰羌佛 看似平淡聖蹟 唯有佛陀能行 此錄影帶中為了保持真實原始實況,從洗缽至甘露降下的整個過程,一幀一秒都沒有剪輯過,
第一次看的人由於不知道持咒修法的時間有多長,時間只有25分鐘,天龍八部、諸佛菩薩就會來到寺廟上空,請大家耐心等待。
「藉心經說真諦」至寶經典法會 意外出現佛降甘露恭賀
文/洛杉磯訊
《藉心經說真諦》實在是至高無上殊勝的經典,此寶書於2014年陽曆3月7日,在美國聖蹟寺首度舉行加持法會,在法台上供奉了《藉心經說真諦》經典寶書,及由七眾行人唸誦修持的六部大法及聖咒和文書法水、楊枝等,前方存放了46枚準備法水加持的《藉心經說真諦》首發式印章。祿東贊慈仁嘉措法王把他親自從H.H.第三世多杰羌佛那裡請到的紫金銅缽,護送到了聖蹟寺,存放在精美堅固、花崗石雕成的祈福台上,由老法王祿東贊和八十多歲的開初仁波切及二十歲的貢嘎仁波切主持法會主角修法,祿東贊法王把缽親自交到開初仁波切手中,經祈禱後,浴沐壇城,再由貢嘎活佛打上清水,當眾洗缽,奉上祈福台,此次參會者全都是仁波切、法師、阿闍黎,大家十分虔誠地開始進入了唸誦六字大明咒和心經。
▲祿東贊法王用甘露領銜的七支聖水加持《藉心經說真諦》首發紀念版的印章、印泥。
法會開始大概十幾分鐘,空中突然狂風捲起,呼嘯鳴響,諸聖護法駕臨,但掛在帷壁上的黃幡緞布,竟然沒有吹捲,此時弟子們各自看到了不同的聖境,殊勝無法言喻!待到經咒停下來時,貢嘎仁波切正準備將六杯法水匯入中央缽中時,他突然穿過透明缽蓋看到缽內出現光芒,定睛一看,原來缽內竟然有非常多的甘露,此時驚喜之外,納頭便拜,頃刻會場一片喜樂之境,各自紛紛進到缽前恭看,有人看到是五彩色,有人看到是紫紅色,有人看到是白色,形體非人間物相,美妙玄提!大家驚喜讚嘆,經過一陣心情喜樂歡嘆,最後六杯法水終於匯入甘露,成為甘露領銜的七支聖水,祿東贊法王將楊枝澆上聖水,灑在首發式印章,加持印泥、印章,並敲響紫金銅缽,以表法音傳遍天際法界,利益六道眾生,福慧圓滿。雖然H.H.第三世多杰羌佛沒有到場修法,但由於佛陀所說《藉心經說真諦》經典所在處,由寶書之無量功德佛力,感召了佛降甘露,一切無上殊勝的聖蹟,徹底證明了H.H.第三世多杰羌佛說法《藉心經說真諦》是最至高無上解脫成就的佛典經藏!
▲大家在現場看到佛陀降下甘露,恭賀《藉心經說真諦》至寶經典。
雖然H.H.第三世多杰羌佛未親自主法修持,但是祂在把缽交給祿東贊法王時說:「我不參加你們的法會了,我相信十方諸佛會加持你們法會的,因為《藉心經說真諦》是最至高無上圓滿的寶書,它會感召加持。」
另外特地告知大家,此法缽於2014年3月23日將會駕臨香港法會,敲響鳴聲為大家祈禱祝福,並與H.H.第三世多杰羌佛2012年返老回春時的對比照片,一併供奉在聖物室中供大家瞻仰法喜。(新聞來源:國際佛教僧尼總會)
原文摘錄至ETtoday新聞雲
完整內容請看《佛陀們認證了第三世多杰羌佛 看似平淡聖蹟 唯有佛陀能行》影片
第三世多杰羌佛所說法《藉心經說真諦》之前言、前序
前 言
在這裡我們法音出版社要澄清一點,今天法音出版社出版的這部經典聖著《藉心經說真諦》,是第三世多杰羌佛藉由《心經》文句義理來說法,闡明心佛眾生的關係,也可以說成是人生宇宙有情無情變異性和非變異性、成住壞空的定義和無成住壞空的真理,佛陀是什麼?眾生與佛陀是怎麼一回事,了生脫死是怎麼一回事,告訴大家什麼是佛法、解脫的真諦。第三世多杰羌佛說法透徹精準易懂,我們只能說是幾千年有佛史以來第一次出現這麼好的頂級寶貝佛書、至高精髓經典。整個全文論述說法都是《藉心經說真諦》,而不是“心經講義”。“心經講義”是另外一本書,早在十幾年前第三世多杰羌佛就已經講著並出版發行了。
三世多杰羌佛所說法之《藉心經說真諦》之前言、前序
為了給《藉心經說真諦》這部聖著作序,我社曾請著名的王者仁波且、碧瞿玉仁波且、摩訶法王執筆,可是他們再三表態,用各種說明佐證自身慚愧、行持還差,只希望自己能真正吃透這部經典付之實用就不錯了,他們說沒有資格在佛書上造句,我們盡了全力也沒能讓他們留下文句。後來我們請莫知仁波且、祿東贊仁波且、丹瑪翟芒仁波且、開初仁波且和拉珍聖德,他們聽說王者仁波且、碧瞿玉仁波且、摩訶法王都沒有寫,第二天他們就給一個理由:“豈敢玷污聖著”,也謝絕了我們的請求。後來我們有幸找到阿王諾布帕母,請她作序,可是收到的同樣是她說無資格在這部經書上造序。無奈之下,我們只得找第三世多杰羌佛,佛陀說:“我隨緣慚愧而說法,寫什麼序啊,能利益眾生才是最好的序。”但是,第三世多杰羌佛已經允諾,祂會找一大批法王、仁波且、法師、居士來為我們這個出版社出版的《藉心經說真諦》法著專門祈禱修法恭請“佛降甘露”和其他聖法。我們聽到這話既無比歡喜又晴天霹靂,歡喜自不用說,震駭的是還沒有聽說過這世上哪個法王仁波且法師有這樣的功德請得動佛陀降甘露!於是我們請示第三世多杰羌佛:“法王仁波且法師們怎麼修得了佛降甘露?”第三世多杰羌佛說:“如果他們修不了,我就更修不了。聖德們多了不起啊,比我有能力啊,人多力量大嘛,你們相信我吧。”佛陀的話讓我們哭笑不得,能相信佛陀的這幾句話嗎?再厲害的法王仁波且能沾上祂十分之一的成就就算神不可攀了,能有什麼資格請佛陀降甘露啊!但是不聽佛陀的話又三業不相應,所以不知說什麼,沒有言語,心中也不敢多想。但我們要恭賀世上行人,佛陀已然允諾修法請佛降甘露,我們將以佛陀從天而降的真精甘露降灑在每一本《藉心經說真諦》上,並且還要舉行法會,加持這部書,凡是我社今後出版的每一本《藉心經說真諦》,都具有特別的殊勝加持力,凡此聖著所在之處,是諸魔鬼不敢以惡害之。第三世多杰羌佛說,所作這一切均是為了防止騙子邪師斷章取義破壞印刷出版,因此其他出版社出版的這部法著,或是某聖德個人印刷的,均一律不作加持,因為若有斷章去句,加文造解,貽害眾生於無始,其駭然之業無法救育,本尊遠離。此類不聽教言之行,看讀非法印行之書,將終身無法取得境行灌頂資格,因百法明門黑關擇決本尊不接受犯行助邪的罪業之人,故不予擇決法緣,無法緣則不能舉行境行灌頂,而不是第三世多杰羌佛不慈悲不灌頂,也不是中地道大聖德師不為舉行灌頂,因為他不敢為破戒印行《藉心經說真諦》的黑業之人違背灌頂。
但頭大的是這序言問題還得要解決,我們總不能拿給非真正聖德人物只有空頭地位的法王尊者來寫序吧。正在一籌莫展之際,國際佛教僧尼總會拉堅尊者二世隆慧法師給我們推薦了真正頂級的巨聖德。第二天,隆慧主席領我們前去拜見巨聖德,說來真是困難,被擋在門外六個多小時,最後聽說我們是為寫序來的,總算見到了巨聖德的侍者,匯報了情況,請侍者轉達巨聖德。巨聖德回覆說:“要讓王者、碧瞿玉、摩訶來寫序,馬上就可以讓他們動筆,但是牽涉到因緣關係他們不適合寫。至於社會上的什麼著名法王尊者,提都不要提,真正說來,莫知他們也是排不上的,但最恰當的還是他們。你們去告訴莫知、東贊他們幾個,就說是我說的,讓他們今天就開始寫序吧。”巨聖老人家帶了一個口信,序言終於解決了。
當我們看了序文以後,非常感動,幾位聖德哪裡是在作序啊,完全是擔負著因果在講心裡話。我社決定把他們的一些實證聖量的資料圖片、和其他一些聖德鐵的事蹟一併刊發在序言中,但願法音出版社能為世界的眾生盡一點綿帛之力,給大家帶來安樂,帶來和平、祥瑞,帶來解脫的聖因,今生福慧圓滿,達證成就的結果、全知起用的涅槃!
法音出版社
西元二零一二年
前 序
我們必須真誠地先對大家講心裡話。
我們幾個根本沒有資格在第三世多杰羌佛《藉心經說真諦》聖著上發言,正如巨聖德老人家說的一樣:“當然排不上你們,哪怕你們在所有的佛書論著上造序作言,也是沒有資格在第三世多杰羌佛的《藉心經說真諦》法著上評談的,只不過你們要為第三世多杰羌佛說的法《藉心經說真諦》說說心裡話。”我們只得照辦。
我們當中,祿東贊、開初仁波且都是七八十歲的人了,我們深知,每時每刻都來不得絲毫說謊摻假,不能錯半點因果,今天說的話必須對佛教、對佛法、對眾生負責,哪怕一句不實在的話都不敢寫在序言中,否則我們短暫的餘生所種下的就不是解脫之因,而是招來黑業罪報、輪迴痛苦,那就真正是最愚笨的人了。
我們幾位都出自藏密各派,深研過顯密二宗,這些都是佛教中的佛法,分宗而立,本源一體。我們曾經在這些法門中修學,用了很大功夫,有些受用,但畢竟無能展顯實際聖量。而真正讓我們有今天這些成就的,是現量大圓滿和金剛換體禪等不帶宗派性的佛法,是佛陀親持執掌的無分別無派性的純正佛教佛法。第三世多杰羌佛沒有任何宗派,就如釋迦佛陀,只有佛教,各宗各派,大乘、小乘,一律平等應機相應眾生弘揚。然而佛陀親傳的頂聖成就法,加持功德力之高是無法想像的,如同釋迦佛陀正法時期,成就證道十分快捷,即是釋迦佛陀親傳頂聖佛法之故。我們修學的攤屍拙火定、現量大圓滿、金剛換體禪、未音禪等,這些法從灌頂受法到修持成就,兩個小時之內可親見聖境、證入聖量,乃至當下進入虹身世界。這是藏傳佛教密宗沒有的法,也是顯宗找不到的,而唯一只有佛陀親持的至高佛法境行灌頂傳的,也就是《藉心經說真諦》的見,《解脫大手印》中的修行和要灌頂所傳的法。
至高佛陀師父第三世多杰羌佛是藉用《心經》的文句、法理,用平實的、口語清談式的語言,把宇宙人生的真諦,把生死輪迴的真相,把心佛眾生、佛陀與我們的關係,把解脫的方法和盤托出。恭學《藉心經說真諦》,我們初看時覺得與古德們講的在理諦上似乎相同,但當細鑒後發現精闢透徹,而且法理高妙無比,確實是前無古聖可及,妙義無窮、深不見底,每聽聞一遍,都有飛躍性的進步,只能說:妙不可言、妙不可言啊!
在過去的學經習論修持中,一直困惑於很多祖師聖德對佛法的最終觀點相互矛盾不統一,各家都好像很有道理,我們在這些論理中淘來淘去幾十年,也無法究竟弄懂誰說的最正確,因為道理畢竟是空的,看不見、摸不著,幾斤幾兩只能口頭說、心裡猜,各有各的理。我們曾問佛陀師父對 × × 大喇嘛的證量有何看法,他的見道怎樣,佛陀師父說我不作評,但他應該是個學者。我們再請問佛陀師父,龍樹提婆師徒、無著世親兄弟、寂天菩薩和唯識論師們誰的佛法正宗高深?佛陀師父說:“佛學理論各有所長,自古宗風各異,見解分歧。龍樹菩薩著有《中論》《大智度論》等弘傳於世,以緣起性空為正見悟理,而無著和世親兄弟則是法相唯識,見上是實有論的主張,就此大乘兩大派系,各持不同見道。依於慈氏《五論》,主要繼承瑜伽師地論點的以世親菩薩為代表,法闡《唯識二十頌》和《唯識三十頌》。玄奘法師以《瑜伽師地論》等為宗,深究發展,著出《八十規矩論》《成唯識論》等論著。唯識之見於空性取義,一切法立各自所緣存在,於現量中非虛假而實有,於圓成實性觀心處則非真實存在,心外無境,認身心實有。寂天菩薩以其《學集》和《經集》一百多部經典要義而有建樹,獨造《入菩薩行》千頌闡述中觀見地,批數論派、勝論派和小乘、大乘唯識見道。而說《入菩薩行》時,自己騰空飛隱,也說明了大乘中觀的知見。唯識見為身心實有,中觀卻相反,見為身心是幻有非實,不是實有的。中觀應成派認為現象外表之相狀是因緣聚合,無常幻顯,實無自性,故隨眾緣離散而消失。公說公有理,婆說婆有理,確實理論見解有高低,實量成果非與同。從現量起見,更重要的是不能忽視了是否有真佛法。因為理論認知的爭持,並非現見解脫的成果,沒有實量成就建立的認知,最終獲得的也是無實量的涅槃。這就如我們從理論上完全可以認識到銀行有很多錢,但事實上不是我們自己擁有的,我們要獲得銀行的財富,只憑認識銀行有很多錢是沒有用的,而是要有合法獲得利益的正當業務,這正當業務就猶如實量的佛法,才能滋生實際的效果。當然,我建議論師們的論學作為助緣也是必要的,你們應作參考。”我們再請問佛陀師父××喇嘛跟這些論師菩薩們相比較,誰的見道更深廣。佛陀師父說:“這個喇嘛是一個好學的人,但是見地愚鈍一些,知見偏頗一些,比你們之前還差那麼一點,以學習論師們的論著為基礎,這也是必要的,社會場合、歷史的慣性,需求佛學滋養見地是應該的,也是必需的。有一句話‘深入論學、開膚智慧’,但要明白,論學是學問的界域。”我們不太明白佛陀師父的話,經大家推敲後,總算悟到了一點,正如祿東贊法王說:如果只研究龍樹、提婆、無著、世親、陳那、寂天、月稱等的論學就能出現實際聖量,進而解決生死問題,那論師們和佛學家與莫知仁波且、開初仁波且就沒有什麼差別了。除了貫通經論外,頭頂骨開口如雞蛋大,神識來去極樂世界,展顯實相,拙火禪功可用自己的身體把人燒傷,這是論學的理論嗎?論學畢竟是空洞的佛學理論,它是以觀照而生實相的基礎而已,如果結合不上真正佛法的實相緣起,論學終歸不是妙有,否則 × × 喇嘛就不是個只講學問都錯誤連篇的喇嘛,而早已妙諳五明。如王者仁波且手掌摸在松杰仁波且頭頂,當下頭髮燒掉,頭頂燒開,流出黑業,去掉了病障,身心暢快,開膚了文字成就。王者仁波且的手掌於現量所見,對唯識來說是地大相狀,而非火大,對應成派而言則是生滅變異之幻有火大,無自性無無常,其上兩派都是理論佛學,並非實際聖量成就。
後來,當我們受到佛陀師父的境行灌頂,深入聖境的當下,以真實的解脫聖境擇照出了誰真誰邊誰不正,終於撥雲見天現真諦。
例如我們本來住在聖境中,只要以過去學的高僧講的般若義理去行持,聖境就會消失退化為凡境。包括玄奘法師翻譯的大般若經六百卷,乃至龍樹、提婆、無著、世親、陳那、寂天、月稱等的論著,也會讓所證聖量停頓不增,包括其他祖師們講的義理。比如睡眠中本來完全清楚是在睡夢,一加入祖師們講的義理來作為鑒道,不到一個月就昏沉了,睡眠中夢境也不知道是夢境了,回歸到凡夫混沌狀態沒有差別。又如修拙火,本來已經修到二段或三段拙火,體溫升高到攝氏八十至九十度,只要加上其他見地入修,幾天之內身體火溫退到五十度,乃至還原到凡夫體溫。而依第三世多杰羌佛《藉心經說真諦》法理,火溫當天明顯提升,聖境現前,本尊出現,護法臨場,頓入三昧之定,並日益殊勝。更神奇的是,依第三世多杰羌佛《藉心經說真諦》和《解脫大手印》頌觀,境界本來殊勝得很,一加上自己的簡短願文迴向,聖境都會快速消失。這時我們才曉得,原來虛空中的護法是不認同任何凡夫文理混入佛陀第三世多杰羌佛所說《藉心經說真諦》和《解脫大手印》的。曾有虛空大護法對祿東贊法王說:“然何忘卻《藉心經說真諦》是受境行大法殊勝加持力被,多一句不可,少一句不可,猶如持咒!”話音剛落,他的境界全然退化,莫知仁波且也有同樣經驗。我們終於悟到《藉心經說真諦》是不能加入減少任何法語的,猶如陀羅尼之微妙故,否則就失掉了境行悉地加持。
《藉心經說真諦》中,佛陀師父說法平淡中藏玄機,細說中開心竅,妙不可言。乃至很簡單的幾句話,與佛法無關的,講故事的口語,竟然一道豪光之後,讓我們頓時萬念空寂了,且時間堅固不散!之前我們其中一人修持《金剛經》時有過類似感受,但時間很短就消失了,當然也許是什麼原因而不相應,除此,任何我們研讀過的經藏論著都不具備的東西,在《藉心經說真諦》中出現了,我們加上受境行灌頂的《解脫大手印》三大心髓合修,威力無窮!!!一股強導性的威力,形成破愚開智的法流,橫掃整個身心迷障,當機應徹本性開悟,強導實量聖境,離戲空洞言論、花言虛理,是任何祖師所講般若、所傳的大法修持無法及其項背的,可令你拜讀中應機分段開悟,乃至大徹大悟,真正是稀世奇絕之無上法寶!
住入實證聖境之後,我們再次將當今一些所謂著名第一流人物講的《心經》拿來研究,才發現這些人連基本的般若諦相都沒有理清。如果說過去我們只是依因明邏輯在理相上有所疑慮,那麼現在則是理體一味的真實徹照,所有偽論、狡辯、敷衍、含混等虛假空洞之說,再也無從遁形。相比第三世多杰羌佛的《藉心經說真諦》,某些聲名顯赫的所謂高僧法王仁波且大法師簡直是表皮術語未入肌膚,法理不明東拉西混,未得聖境天地之別。
在全世界佛教徒中,有禪和子和經教子兩種人,這些人大多是地位較高的著名人物。經教子又分兩類:一為順理經教子,二為湊混經叫子。順理經教子是將經句原文列出後搬抄祖師們所講論學原文,以符合所講經句之義,這類人是數他人珍寶,無自悟證量。湊混經叫子,是將所講原句列出後,搬抄祖師們講的論學、論句,但與所應講的原句無關,胡亂拼湊在一起騙外行,這是不懂經藏論學的流混子。包括許多大法王、大尊者,乃至有宗教領袖頭銜的人物,同樣脫離不了這類不懂經藏論學的流混子本質。比如要講“觀自在菩薩,行深般若波羅密多時”這一句,而所講的內容脫離經句含義,沒有講什麼叫“觀自在”,什麼叫“菩薩”,什麼叫“行深”,什麼叫“般若”,什麼叫“波羅密”,什麼叫“多時”,實際上他不是不講,是他講不出來,他不知道含義,在這種沒有辦法的情況下,只好搬抄與這一句不相干的祖師論學原文或論句術語,翻來覆去東拉西扯,反正世人又聽不懂,只認為是在說空理,就這樣欺騙外行,混堂過關。這就是地道的湊混經叫子,對經喊叫、不通經教、摘句拼湊、混子亂鬧,故此類人稱為矇騙行人的邪師混子。凡遇此類,包括那仁巴格西、登峰頂級的俄燃巴格西,同樣概為不懂裝懂的混子、亂世邪師!行人要倍加小心。祿東贊法王、開初仁波且等也曾被一位十三歲的學童迷惑,因為看到這小孩的一篇《心經》講稿,大為吃驚,誤認為此世界竟有如此了得的聖者出世了,於是當日前往拜見。交談中發現那小孩什麼教法也不懂,問他講《心經》的妙法所在,小孩說他五歲就開始讀龍樹、提婆、陳那、無著、世親、寂護、月稱的論學,他講的《心經》是立出要講的句法以後,再把論學裡面講空講緣起等句子抄下來湊合起來,有一點沾邊的就抄,一點也不難。幾個人大為慚愧,竟然被一個湊混經叫子戲弄了,而且是一小孩子戲弄。
所以,為了大家真正學到佛法,在此我們建議有緣善信們,最好先不要看第三世多杰羌佛的《藉心經說真諦》,這一點太重要了,而要先找到當今世界的大人物法王尊者大師們或古德祖師們講的心經講義和論著,或禪門開機之法,或講明心見性、法性真如、般若等等的論述來看,有了認知以後,再開始拜讀第三世多杰羌佛說的法《藉心經說真諦》,這時你會清楚認識到什麼是鑽石寶貝,什麼是塑料鍍金,正法與邪師一目了然。
我們要提醒行人,《藉心經說真諦》是至高無上的成就解脫真諦,所以是妖人、魔類之敵,凡是妖孽均會見之生恨,視如大敵當前,他們會採取各種手段詆毀誹謗第三世多杰羌佛及《藉心經說真諦》經著。但無論這些人引什麼經、據什麼典、搬出什麼樣的儀軌法義,無論他們的身份是什麼樣的至高傳承,無論他們有幾十萬幾百萬弟子,無論他們怎樣語驚四座、口若懸河,你們會看到一個辯白不了的事實:他就是改變不了他的本質,他必然是五明平淡無奇乃至不通,經教學識膚淺,凡夫境界聖量不顯,肉體凡骨未結聖胎,這就是他改變不了的凡夫本質結構。所以,只要他拿不出相應的實際本事展顯在你們面前,他所有的論述說辭都是騙人的,無非三個結論:
1. 他沒有真正懂得經教法義的含義而歪曲亂講。此人絕無實際聖量功夫!
2. 他所借鑒的理論法義本身是假的,所以此人沒有聖量功夫實顯!
3. 他雖然身著高僧大德之裝,但其本質是凡夫或妖魔充當聖位,藉用經典論著遮身,所以得不到正法加持才沒有實際本事展顯。
你們注意觀察一個事實,凡此上空洞理論者,凡誹謗第三世多杰羌佛及《藉心經說真諦》經著者,其鐵定的共性是:沒有一個人能展顯得出聖量來。為什麼?因為是假的,就真不了。他們教不出弟子真功夫,自己也沒有任何聖證量本事,而只有四大黑業、身心不調、假慈悲、喪失人性,講拙火自己修不出拙火升高體溫,講開頂自己開不了頂,講大圓滿弟子見不到虹身世界,身體結構裡裡外外與凡夫毫無差別,根本就是講空洞理論的假聖人。這就是以假充真的空洞凡夫現象,這就是邪惡騙子們想遮也遮掩不了的事實,任何說辭都逃避不開的真相。至於他們口頭講的聖智慧五明成果,他們死也拿不出來,不信你們去查,他們超越專家的五明成果每一明擺在哪裡的?哪裡有陳列?記住,是成果,不是文字名詞。
佛弟子們,佛陀說法是為開示眾生實證成就得解脫的,不是拿給徒有虛名的騙子人物混嘴皮子坑蒙眾生錢財的,任何法王仁波且法師所說的法義,如果僅只在祖師們論著的理論術語上搬來抄去,沒有實際聖量展顯,那就說明他講的法理是藉論矇騙於人。你們想一想,實際聖量都沒有,怎麼會有最終的成就、全知涅槃呢?這不是騙你的嗎?
佛陀師父說的十二問語,是照妖鏡、鑑寶杖,是找到真佛法的指路明燈。佛陀師父說:“你自問:為何學佛?為了生死。依何了脫?真實佛法。何為真法?離虛實顯。怎擇聖師?空論非聖。真法怎鑑?實顯理真。假法何分?空理無實。”把這十二句問語弄懂了,自然照出假聖,找到真師,學到如來正法。一切聖法皆是要實量實顯,並非空洞理論能代表得了的。比如金剛換體禪,或現量大圓滿,只要兩個小時之內弟子將會親自見到聖境,就知道真假了。比如確定性觀照法緣、身份、預測乾坤雲夢得的擇決,是至少中地道師資的道量,該師準確無誤地先知定論後,弟子在伸手不見五指的黑關中,從他自己書寫打成密團的一百道文書中摸拿出三張,這三道文書與師公眾預言毫無差別、一字不錯,只需一個時辰便見其師道量真假。
我們今天的成就,全是因為佛陀師父說法的《藉心經說真諦》和《解脫大手印》三大心髓具備的無上正等加持力,其言語之間藏著無窮奧妙、強大威力,完全不同其他人傳的法。不說深了,僅就世法受益而言,如開初仁波且,學法前身體很差,全身病痛老態龍鍾,終年腰酸腿痛咳嗽感冒不停歇,嚴重過敏、三高病癥、神經衰弱失眠等等,這樣那樣的病症弄得他寢食難安。經佛陀師父傳境行灌頂,學習《藉心經說真諦》後,病痛不見蹤影,整日神清氣爽健步如飛,到台灣檢查身體,醫生說他一點毛病都沒有,身體健康指標如同三十幾歲年輕人,且悟徹菩提心妙理,斷魔歸本徹真如。佛弟子們,佛陀師父第三世多杰羌佛說的第一義諦才真正能徹應本性、真空妙有、體顯實相境界啊!
於此,我們再次希望行人提前閱讀其他大德高僧們的心經講義,或對心經的論說,千萬要在第三世多杰羌佛《藉心經說真諦》出版之前就看,建立廣泛認知,才能將法理對比,識別真假聖德,否則《藉心經說真諦》出版公開發行後,你們再去應證有質疑的法王大德高僧,有些人已認真修學第三世多杰羌佛說法由邪轉正當然好,只怕有些執迷不悟的邪師會搬出第三世多杰羌佛的教論遮身,若一時沒有警覺查其證量,單從理論方面,你們或許很難辨別這位上師的程度、真假、類型,就容易上當了,乃至可能終身迷在所謂傳承來頭大人物、實則騙子邪人的手中,陷入輪迴痛苦,永無解脫了。
這序言的文句,想必有些人會覺得為什麼我見這麼重,你們幾個為什麼只說自己好,不說他人好?這種寫法太愚笨了嘛,無疑會招人憎恨反感的。這個簡單的處世之道“驕則損、謙受益”我們幾個懂得,但我們只能說心裏話,不能說不真實的好聽話。我們發了誓要為因果承擔責任,讓大家學到真正的佛法,只能如語、實語、不妄語,否則因果報應我們承擔不起。比如說到五明,事實就是從古至今幾千年佛史,除了第三世多杰羌佛,再沒有第二個拿得出如此完美無缺的巔峰五明成果,就是釋迦牟尼佛也是在其他世界展顯登峰五明,這是鐵打的事實,我們總不能站在第三世多杰羌佛的三十大類五明成果面前睜著眼睛說瞎話,總不能說第三世多杰羌佛不具五明,而那些拿不出任何超凡五明成果的法王尊者仁波且才是五明巨匠吧?比如那些宣說拙火定自己身體卻升不了溫、開不了頂、完全是凡夫結構的喇嘛、仁波且、法王、法師,不但沒有實際成就本事,講的理論都錯漏百出胡說八道,乃至全西藏全世界都找不出一個他們的門人能真正升起拙火溫、能真正開頂、能真正聖力外用。他們最會迷惑人的一套就是搬出自己的上師,或上師的上師,吹噓成修什麼什麼了得的功夫成就的,拿這些看不見摸不著,早就不在人世的人來作空洞理論的支撐,其實都是假的。要不然就弄一些看不到事實的空洞宣說錄影帶,如拙火,只能拍一個誰都拍得出來的紅影像,卻沒有具體的溫度;只能看到插香插吉祥草,而沒有實際的頭頂開口;只會吹噓說神識飛遷,卻看不到神識;只會吹噓說大圓滿而弟子看不到虹身世界,只會吹噓說空洞擇決而不敢行文預言等等。我們總不能睜眼說瞎話,總不能說這些喇嘛法王法師開頂幾指寬、神識外用、化虹飛身、先知預言、徹見本性、已經大成就吧?我們今天就來一個直白的、透明的、一眼看穿的提問吧:就拿拙火來舉一個例,很多人都知道拙火定這個功夫,但是,你們能在這個世界上指得出有名有姓真正能升得起拙火體內高溫、隨意除病的這樣一個人嗎?明確告訴你們,找不到吧。這就是誰也無法遮蓋、辯駁不了的事實。我們怎麼能把沒有的事說成有呢?相反的,第三世多杰羌佛的弟子中,隨處都能找到真正的拙火功夫,他們都活生生的在這個世界上,有名有姓,有科學驗證等等,在鐵的事實證據下,我們怎麼能不寫事實呢?不要說這些生活中的人修成聖者的實例了,就僅憑舊金山華藏寺現有存在的佛陀在虛空降下甘露到缽中的缽、巨聖德先知預言的金瓶、肚腹升起拙火燒炒“喀卓安得丸”的瓷鍋、兩位聖德抬動四千二百六十多磅的浴佛蓮池、迎接《多杰羌佛第三世》寶書時降甘露的木棉花樹、浴佛池中大放豪光的法王子像等等聖跡聖物,在這個地球上,沒有哪一個寺廟有這麼多真正佛法展顯的聖物,無論是密宗寺廟還是顯宗著名寺廟都辦不到!至於常見的釋迦牟尼佛舍利,和第三世多杰羌佛的弟子成就後化虹出顯的堅固子、肉身不壞、生死自由那就太多了。這些聖跡是現在的、實在的,時間地點人物都真真實實的,這些人和事就活生生發生在我們的現實生活中,而不是談古論今講故事虛幻夢影的傳說。你能指得出舊金山華藏寺以外還有哪個寺廟有這麼多聖跡?當然,當今的佛教界,各宗各派有不少大佬級的法王尊者乃至名震世界的大人物到處以佛菩薩身份自居,敢吹噓自己什麼聖境功夫都證到了,可實際中就是沒有一項真實的成果擺得出來。他們不管是真是假,不顧因果報應、眾生慧命,敢儼然登坐高臺以假亂真、故弄玄虛、顛迷信徒,周圍的人也被他們的傳承、遊說迷昏了頭、不實際考證他們的成果聖量就跟著亂吹捧。但我們是佛陀的弟子、慚愧的心行,我們要修行,我們要解脫,我們怕錯因果,我們只能說真實來寫這篇序言,不敢說只討大家喜歡的假話、不實在的話,所以請大家諒解。我們講得再多也沒有用,你們還是去真誠恭敬地拜讀修學第三世多杰羌佛的《藉心經說真諦》,會自然從內心中明瞭什麼是至高無上,什麼是真正佛法,由此而獲證不同之相應開悟。
我們相信,有人看了我們的序言後,會非常嫉妒憤恨,十分惱火,因為幾千年來沒有人砸他們的招牌、打他們的痛處,所以他們不得不奮不顧身跳出來大肆誹謗,罵我們幾個不是如語實語,在虛吹浮誇,是脫離佛陀教誡的,不合經教;罵《藉心經說真諦》如何如何不好,而他講的才如何如何好,如何符合經教,如何正法。你們這些妖僧邪師,我們只要問你們幾句,就會讓你們丟底現眼!你們說你們如何合法了得,你們為什麼是凡夫之體毫無功夫呢?你們修得起拙火功夫嗎?你們的頭頂開了幾指寬呢?一指還是兩指呢?基本的神識外用都達不到嗎?你們能當著眾人請佛陀從虛空降下甘露來嗎?你們明心見性了、能感召三洲嗎?答案是:你們毫無功夫,一樣也不能!因為你們講的是假理論,你們沒有學懂真正的經藏法義,還在佛門外面,所以你們才是凡夫一個、百無一能、只會吹噓,好可憐,拿不出本事證明自己超凡入聖。記住,你們誹謗羌佛的人,是假理論、造罪人,說假話騙騙人而已,把你們的面紗揭開,你們就是這個樣子!可我們才是如語實語、符合佛陀教誡、沒有虛吹浮誇的,已經實實在在拿出實際的佛法擺在了大家面前,證明了第三世多杰羌佛的《藉心經說真諦》和《解脫大手印》是無聖可及的頂聖佛法!我們就是修《藉心經說真諦》和《解脫大手印》得到的成就!我們的成就絕不是你們的假理論能達到的!
另外提醒大家,切不可聽信任何一個無論什麼地位之上師的膚識偏見開示,你們如果不信,就等到你們拜讀過第三世多杰羌佛說法的《藉心經說真諦》,稍有一點點懂的時候,你們再回過頭去看你們依止的法王、尊者、大法師、大活佛,曾經給你們講了什麼?是內行嗎?懂佛法嗎?可以說是錯誤百出,大牙都要笑掉,這時候你們才會明白,不是大聖德、巨聖德,哪裡懂得了佛法啊?!所以才再三規定不能聽任何人講的開示,只能聽聞第三世多杰羌佛的法音,任何人的講解開示都可能是邪見錯誤,甚至連基本法義都沒鬧懂,想當然亂編瞎湊,必然誤導你們走入邪途的!!
願三界六道一切眾生均能受到第三世多杰羌佛說法之洗滌,依持如來正法,解脫定然無礙!
三寶弟子、慚愧行人:莫知
祿東贊·慈仁嘉措
丹瑪翟芒·隆智
開初
拉珍
共同發自內心的真話
西元二零一二年
1.南無第三世多杰羌佛說法《藉心經說真諦》001 前言 P5-7 普通話恭誦

001南無第三世多杰羌佛說法《藉心經說真諦》前言 P5-7 普通話恭誦
這部經典聖著《藉心經說真諦》,是 H.H. 第三世多杰羌佛 藉由《心經》文句義理來說法,闡明心佛眾生的關係,也可以說成是人生宇宙有情無情變異性和非變異性、成住壞空的定義和無成住壞空的真理,佛陀是什麼?眾生與佛陀是怎麼一回事?了生脫死是怎麼一回事,告訴大家什麼是佛法、解脫的真諦。H.H. 第三世多杰羌佛 說法透徹精準易懂,我們只能說這是幾千年有佛史以來第一次出現這麼好的頂級寶貝佛書,至高精髓經典。
2.南無第三世多杰羌佛說法《藉心經說真諦》002 五聖德前序 P8-10 普通話恭誦2

南無第三世多杰羌佛說法《藉心經說真諦》002 五聖德前序 P8-10 普通話恭誦2
這部經典聖著《藉心經說真諦》,是 H.H. 第三世多杰羌佛 藉由《心經》文句義理來說法,闡明心佛眾生的關係,也可以說成是人生宇宙有情無情變異性和非變異性、成住壞空的定義和無成住壞空的真理,佛陀是什麼?眾生與佛陀是怎麼一回事?了生脫死是怎麼一回事,告訴大家什麼是佛法、解脫的真諦。H.H. 第三世多杰羌佛 說法透徹精準易懂,我們只能說這是幾千年有佛史以來第一次出現這麼好的頂級寶貝佛書,至高精髓經典。
3.南無第三世多杰羌佛說法《藉心經說真諦》 五聖德前序 P11-14普通話恭誦

南無第三世多杰羌佛說法《藉心經說真諦》 五聖德前序 P11-14普通話恭誦
這部經典聖著《藉心經說真諦》,是 H.H. 第三世多杰羌佛 藉由《心經》文句義理來說法,闡明心佛眾生的關係,也可以說成是人生宇宙有情無情變異性和非變異性、成住壞空的定義和無成住壞空的真理,佛陀是什麼?眾生與佛陀是怎麼一回事?了生脫死是怎麼一回事,告訴大家什麼是佛法、解脫的真諦。H.H. 第三世多杰羌佛 說法透徹精準易懂,我們只能說這是幾千年有佛史以來第一次出現這麼好的頂級寶貝佛書,至高精髓經典。
此文章連結 : https://history-of-buddhism.com/2020/12/28/第三世多杰羌佛說法《藉心經說真諦》/
依法圓福慧 : https://history-of-buddhism.com/

在〈第三世多杰羌佛說法《藉心經說真諦》〉中有 4 則留言